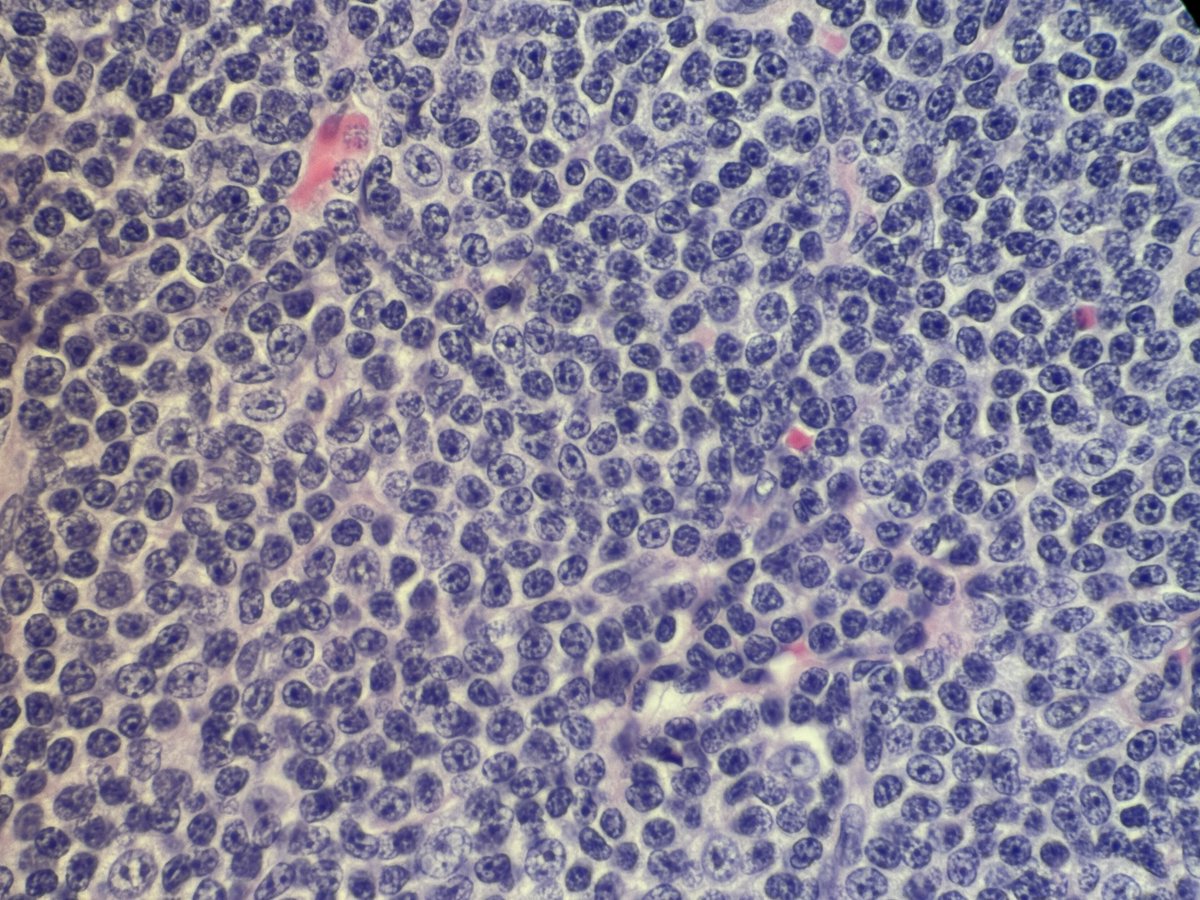
#Hemepath #Surgpath #Pathology Multiple neck lymph nodes. It is obviously a Lymphoma. I requested immunostains to classify. Your preliminary diagnosis ?
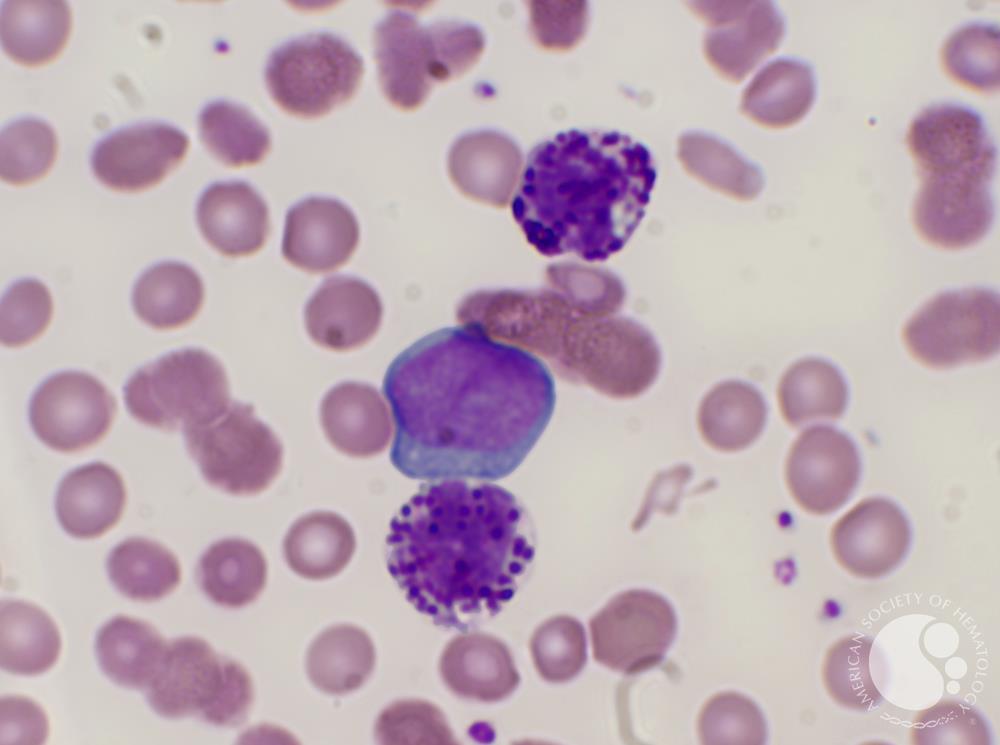
A 67 yr old ♀️ presents with fatigue and epistaxis 🩸

Pancytopenia on blood work

Myeloid blasts on blood smear 👇🏽

What's the most likely cytogenetic abnormality?

Siddharth Bhattacharyya, MD
@siddhar35280812
Hematopathologist #pathology #pathtwitter #hemepath
ID: 1149560646700294144
12-07-2019 06:06:30
1,1K Tweet
3,3K Followers
2,2K Following


(1/5) Key points from today's amazing lecture by LJMedeirosMD : Major mutations in pathways involved in DLBCL+ potential targets that can be assessed by IHC, summarized in the pics below #hemepath #hemepathmda #virtualpath #virtualhemepathmda Kirill Lyapichev MD Anderson Cancer Center